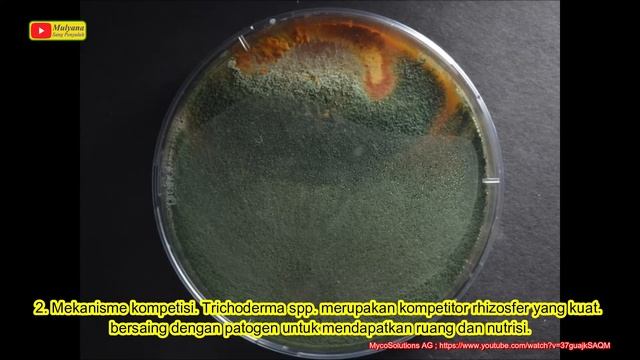
Mikroorganisme Menguntungkan Bagi Tanaman 1. Trichoderma sp. Fungi Pemberantas Fungi смотреть онлайн

Автор: Грибные скульптуры Страница 2

Гриби я утону в твоіх глазах

Задвижки линии дросселирования ПВО #епихин #буровойликбез #бурение #пво

Ելակով պաղպաղակ🍨🍓 Клубничное Мороженое🍨 🍓Strawberry Ice Cream🍨🍓

ночь город темиртау.

бегущие строки

How Seed Oil Consumption Turns Body Fat Into a Toxin-Generating Machine; Dr. Catherine Shanahan, MD

Minecraft - Лето - Серия#6 -Карер

Грибы а горах. Белые грибы 2023

Bitki Doktorları 64 - Toprak Kökenli Fungal Hastalıklar ve Solarizasyon

Белый гриб

Донецк Donetsk mushroom cloud ( tactical nuke ?) 31 08 2014 грибовидное облако

Поход в парк "Веселка"

Возвращение с леса без грибов

天气太冷,丹丹烧一锅酸辣汤,麻辣鲜香汁浓肉厚,泡大饼吃太香了【胖手手丹丹】

грибы

Учим турецкие слова в картинках с примерами. Урок 10. Дикие животные в турецком языке

Грибы-Тает лёд пародия

решение шахматных задач на сайте chess.com на выживание

AP Biology - Saccharomyces Cerevisiae

Fusarium wilt of tomato #Msc_botany #diseases_of_tomato#plantpathology
Mikroorganisme Menguntungkan Bagi Tanaman 1. Trichoderma sp. Fungi Pemberantas Fungi

NeadekvatTV - Райдеры с колхозки (1 серия).wmv

kizaru feat. Duke Deuce - Playa speed up

"Письмо к женщине". Сергей Есенин.
За каждым успешным каналом стоит личность, идея и сотни часов кропотливого труда. Если вы здесь, значит, автор «Грибные скульптуры» уже сумел зацепить ваше внимание своим уникальным стилем или подачей. А мы на RUVIDEO позаботились о том, чтобы вы могли изучить весь архив его работ в максимально комфортных условиях — без лишней суеты и преград.
Почему за работами канала «Грибные скульптуры» так интересно наблюдать? Всё просто: это честный контент, который находит отклик в сердцах зрителей. На нашем ресурсе вы можете смотреть онлайн все видео любимого автора бесплатно и в хорошем качестве. Нам важно, чтобы вы видели каждую деталь и слышали каждый нюанс, поэтому мы используем только стабильные плееры из открытых источников Rutube.
Следите за новинками канала, пересматривайте старые шедевры и открывайте для себя новые грани творчества «Грибные скульптуры». Мы постоянно обновляем ленту, чтобы у вас под рукой всегда были самые свежие выпуски. Никаких сложных регистраций — только вы и творчество, которое вдохновляет. Приятного вам путешествия по миру авторского контента на RUVIDEO!
Видео взято из открытых источников Rutube. Если вы правообладатель, обратитесь к первоисточнику.